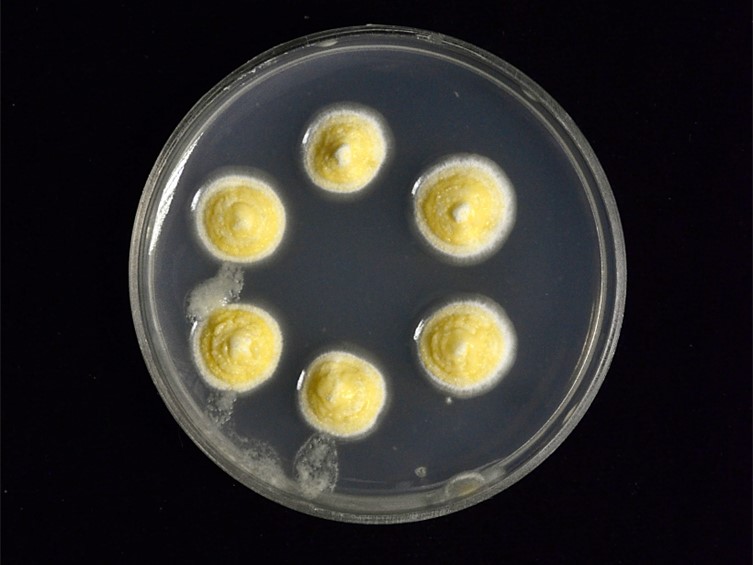

Holotype:
THAILAND, Kanchanaburi Province, Takhian Thong Waterfall Nature, 9 Jan. 2013, A. Khonsanit, S. Mongkolsamrit, W. Noisripoom, holotype BBH 40814, ex-type living culture BCC 75981.
Habitat:
Underside of bamboo and dicotyledonous leaves.
Host:
Scale insects (Coccidae).
Description:
 Asexual morph: stromata flat to umbonate, globose to subglobose, 1-7 mm in diam, 1-1.5 mm in thick, white, light yellow to strong orange yellow conidial masses.
Asexual morph: stromata flat to umbonate, globose to subglobose, 1-7 mm in diam, 1-1.5 mm in thick, white, light yellow to strong orange yellow conidial masses.  Conidioma scattered around the center of stromata, widely open orifice, irregular or U-shaped, 200-350 × 150-250 μm.
Conidioma scattered around the center of stromata, widely open orifice, irregular or U-shaped, 200-350 × 150-250 μm.  Phialide hyaline, cylindrical, 10-50 × 1-1.5 μm.
Phialide hyaline, cylindrical, 10-50 × 1-1.5 μm.  Conidia hyaline, narrowly fusiform, 10-14 × 1.5-2 μm.
Conidia hyaline, narrowly fusiform, 10-14 × 1.5-2 μm.  Paraphyse present, hyaline, filiform, up to 110 μm long, 1-1.5 μm wide. Sexual morph: stromata raised, 2-3 mm in diam, white. Perithecia scattered, semi-embedded, numerous perithecia per stroma (≥5). Ostioles pale green. The sexual morph of M. kanchanaburiensis is immature; we could not observe the size and shape of perithecia, asci, asci caps, and ascospores.
Paraphyse present, hyaline, filiform, up to 110 μm long, 1-1.5 μm wide. Sexual morph: stromata raised, 2-3 mm in diam, white. Perithecia scattered, semi-embedded, numerous perithecia per stroma (≥5). Ostioles pale green. The sexual morph of M. kanchanaburiensis is immature; we could not observe the size and shape of perithecia, asci, asci caps, and ascospores.
Culture characteristics:
Colonies on PDA compact, convex to pulvinate, flat in the margins, attaining a diam of 9.5–11 mm in 2 wk, white with brilliant greenish yellow conidial masses. Colony reverse brilliant greenish yellow, white in the margins.
Colonies on PDA compact, convex to pulvinate, flat in the margins, attaining a diam of 9.5–11 mm in 2 wk, white with brilliant greenish yellow conidial masses. Colony reverse brilliant greenish yellow, white in the margins.
Reference:
Khonsanit A, Noisripoom W, Mongkolsamrit S, et al. (2021). Five new species of Moelleriella infecting scale insects (Coccidae) in Thailand. Mycological Progress 20: 847–867.
DOI: https://doi.org/10.1007/s11557-021-01709-5Species |
Strain |
Compound |
Pubchem CID |
Biological activity |
Reference |
|---|
|
Strain |
LSU | RPB1 | TEF1 |
|---|---|---|---|
| BCC 75979 | MT659363 | MT843900 | MT672279 |
| BCC 75980 | MT659364 | MT843901 | MT672280 |
| BCC 75981 | MT659365 | MT672281 |